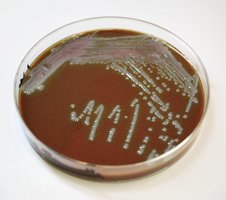
Chocolate agar with Francisella tularensis
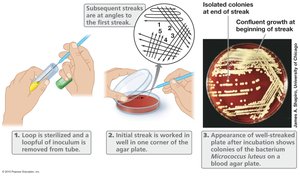
Streak plate method for isolation of pure culture

Back
BackMicrobial Growth: Nutrition, Cultivation, and Enrichment
Study Guide - Smart Notes

Microbial Nutrition and Growth
Cellular Composition and Nutrient Requirements
Microbial cells require a variety of nutrients for biosynthesis and energy production, which are essential for growth. The cell mass consists primarily of water and dry mass, with macronutrients and micronutrients contributing to the dry mass. Macronutrients are needed in large amounts, while micronutrients are required in trace amounts. Most often in nature, microbial growth is limited by the availability of these nutrients.
Macronutrients: Carbon, nitrogen, phosphorus, sulfur, magnesium, potassium, calcium, and sodium.
Micronutrients: Iron, zinc, copper, manganese, cobalt, molybdenum, and others.
Growth Factors: Organic compounds such as vitamins, amino acids, purines, and pyrimidines that some microbes cannot synthesize and must obtain from the environment.
Nutrient Limitation Example: In ocean environments, iron is a limiting nutrient for the growth of algae.


Culture Media: Types and Composition
A culture medium is a semi-solid or liquid preparation used to grow microorganisms, containing all required nutrients for the organism to be cultivated. The composition of culture media must be tailored to the nutritional requirements of the microbe. Solidifying agents such as agar (1.5% w/v) are commonly used.
Defined (Synthetic) Medium: All chemical constituents are known and precisely measured.
Complex (Undefined) Medium: Contains ingredients of unknown exact composition, such as tryptone, peptone, yeast extract, and casamino acids.

Minimal vs. Rich Media
Growth media can be categorized based on the nutrient content:
Minimal Medium: Contains only the essential nutrients required for growth.
Rich (Enriched) Medium: Contains additional nutrients to support the growth of fastidious microorganisms.

Diagnostic and Undefined Media
Blood agar is a commonly used undefined diagnostic growth medium, useful for identifying hemolytic activity and supporting the growth of a wide range of bacteria.

Sterilization of Growth Media
All growth media must be sterilized before use to prevent contamination. Sterilization can be achieved by heat (autoclaving) or filtration.
Autoclave: Uses steam under pressure (121°C, 15 lb/in2, minimum 15 minutes) to kill all organisms and spores.
Filtration: Used for heat-sensitive media components.

Differential and Selective Media
Definitions and Applications
Selective and differential media are essential tools in diagnostic microbiology for the identification and isolation of specific microorganisms.
Selective Medium: Contains agents that inhibit the growth of certain microbes while allowing others to grow.
Differential Medium: Contains indicators that reveal differences in metabolic activity among microbes, often resulting in color changes or other visible reactions.
Combined Media: Some media formulations are both selective and differential, aiding in identification and isolation.


Diagnostic Test Kits
Diagnostic test kits, such as the API 20A and Enterotube® systems, utilize multiple selective and differential media to identify bacteria isolated from patients.


Blood Agar as a Differential Medium
Blood agar is a common differential medium used to detect hemolytic activity of bacteria. After incubation, different hemolysis patterns can be observed.


Isolation and Enrichment of Pure Cultures
Pure Culture Isolation
Most microbes exist in complex communities. To study a microorganism or perform diagnostic identification, it is necessary to isolate a pure culture. Aseptic technique is used to prevent contamination during manipulation of cultures.

Streak Plate Method
The streak plate is the most common method for isolating pure cultures. It involves spreading cells on a petri plate using an inoculation loop to obtain isolated colonies.
Agar Dilution Tubes for Anaerobes
Agar dilution tubes are used to isolate colonies of anaerobic microorganisms, resulting in colonies embedded in agar.

Enrichment Cultures
Enrichment cultures use growth media containing nutrients required for specific members of a microbial community. This technique increases the abundance of microbes capable of carrying out specific metabolic processes, such as petroleum degradation.


Growth in Different Media
Growth Rate Comparison
Escherichia coli grows at its maximum physiological rate in LB medium. 2xYT is the same as LB but with twice the nutrients, resulting in faster growth. The composition of media affects cell density and growth rate.
Tryptone: Trypsin digest of casein (milk protein), providing amino acids and peptides.
Yeast Extract: Water extract of dried yeast cells, supplying many nutrients.

Summary Table: Macromolecular Composition of a Cell
Macromolecule | Percent of Dry Weight |
|---|---|
Protein | 55 |
Lipid | 9.1 |
Polysaccharide | 5.0 |
Lipopolysaccharide | 3.4 |
DNA | 3.1 |
RNA | 20.5 |
Summary
Cells are composed of water, macronutrients, and small amounts of necessary micronutrients. Nutrient requirements vary depending on the microorganism.
Growth media can be defined (all exact chemical constituents are known) or undefined. Media can also be enriched or minimal.
Selective media allow only specific subpopulations of organisms to grow.
Differential media provide a biochemical test for specific metabolic pathways.
Growth media can be sterilized in an autoclave, where it is heated at 121°C for a minimum of 15 minutes at 15 lb/in2. The heat kills all organisms and spores, and the pressure prevents evaporation of water from the growth media.
